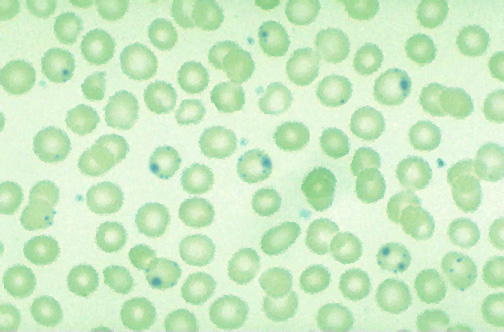

| This peripheral blood smear with methylene blue stain shows Heinz body inclusions in red blood cells. Inherited disorders of RBC enzymes may lead to hemolytic anemia. One of the most common of these is glucose-6-phosphate dehydrogenase (G6PD) deficiency, an X-linked disorder found in 12% of African American males. It is also seen in persons from around the Mediterranean region, including Italy, Greece, and Turkey. The biochemical defect is in the hexose monophosphate shunt, which is important in protecting the RBCs from oxidation. Exposure of older RBCs to certain oxidizing chemicals, particularly drugs such as antimalarials (quinine derivatives such as primaquine), sulfa, nitrofurantoin family, aspirin, and phenacetin leads to hemolysis. Foods such as fava beans may have a similar effect. Most cases of G6PD deficiency are asymptomatic until there is a precipitating infection, or the patient takes an oxidizing drug. Laboratory findings may include anemia, reticulocytosis, indirect hyperbilirubinemia, and decreased haptoglobin. The definitive diagnosis is made by quantitative enzyme assay. |
![]() |